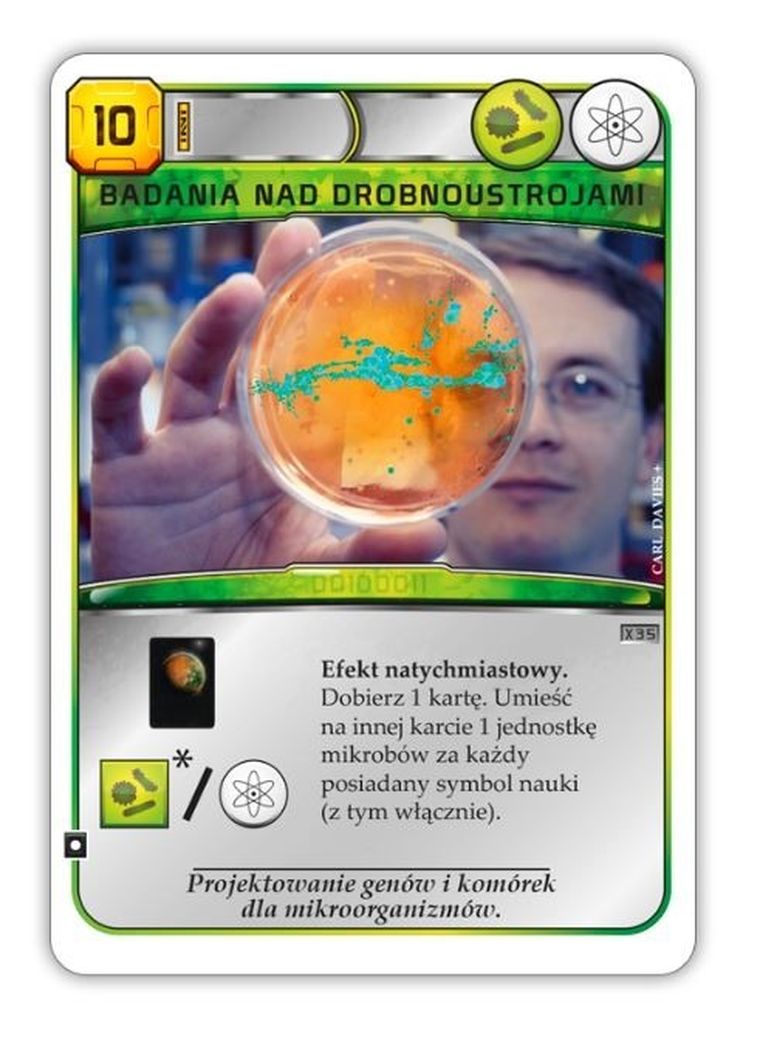
Rebel, Terraformacja Marsa: Zestaw dodatkowy 6 i 7, dodatek do gry

Terraformacja Marsa - Zestaw dodatkowy #6 Zwiększ swoje możliwości inwestowania w wielkoskalowe projekty kosmiczne dzięki Prawu do asteroid! Ta dodatkowa karta dobrana i zagrana w odpowiednim momencie może zapewnić Ci nie lada przewagę, zapewniając stały dostęp do jednostek tytanu lub możliwość zwiększania produkcji kredytów. Niezależnie czy dążysz do zdobycia nagrody Bankiera, czy masz w planach śmiałe (i drogie) inwestycje w projekty z symbolem przestrzeni kosmicznej, warto zwrócić na nią uwagę! Terraformacja Marsa - Zestaw dodatkowy #7 Bądź na bieżąco z najnowszymi projektami wspierającymi marsjańską kolonizację i zainwestuj w nie cenne kredyty Twojej korporacji! W tym zestawie znajdziesz 4 karty projektów, które możesz dołączyć do talii podstawowej w swojej Terraformacji Marsa: Uwaga! To nie jest samodzielna gra! Do rozgrywki wymagana jest podstawowa wersja gry: Terraformacja Marsa (edycja Gra Roku). Dodatkowe informacje: Pasujące koszulki na karty: classic card game (63.5x88 mm) - 5 szt.
Nr produktu: 7292367
:
Producent
:
Przedział wiekowy
:
Płeć
:
Marka
:
Nazwa przedmiotu
:
Licencja
:
Licencja Lego
:
Rozmiar
:
Kolor łóżeczka
:
Materiał zewnętrzny
:
Permanent
:
Buty
:
Aparat foto (mpix)
:
Bateria
:
Rodzaj baterii
:
Bielizna
:
Cechy fotelika
:
Cechy leżaczka
:
Cechy piórnika
:
Cechy plecaka
:
Cechy wózka
:
błędny
:
Czas pracy na akumulatorze
:
Czas trwania
:
Czy produkt wysyłany losowo?
:
Czytnik kart?
:
Autor
:
Długość wkładki
:
Długość wkładki (cm)
:
Dotykowy ekran
:
Dubbing polski
:
Format
:
Format dźwięku
:
Format pliku
:
Format video
:
Gatunek
:
GPS
:
Gramatura (g)
:
Liczba graczy
:
Liczba klocków
:
Liczba kół
:
Liczba nośników
:
Liczba sztuk w opakowaniu
:
Ilustrator
:
Jakość zapisu video
:
Jeans Fit
:
Język
:
Karta graficzna
:
Karta pamięci
:
Klasyfikacja ADAC
:
Klasyfikacja PEGI
:
Koła wózka
:
Lampa
:
Lektor
:
Lektor język
:
Lektor (tak/nie)
:
Liczba kartek
:
Liczba rdzeni
:
Materiały dodatkowe
:
Modem
:
Napisy
:
Nuta zapachowa - On
:
Nuta zapachowa - Ona
:
Obsada
:
Okrycia
:
Oprawa
:
Liczba stron
:
Pamięć RAM (GB)
:
Pamięć wewnętrzna
:
Permanent
:
Platforma
:
:
:
:
:
Zwiększona wytrzymałość
:
Zoom optyczny kamery
:
Zoom optyczny aparatu
:
Zoom cyfrowy
:
Zdjęcia 3D
:
Zdalnie sterowany
:
Zawartość pudełka
:
Wzór, aplikacja, motyw
:
Wysokość buta
:
Wymiary
:
Wymiary materaca
:
Wymiary łóżeczka
:
Wymagania sprzętowe
:
Wykonawca
:
Wyjście HDMI
:
Wydawnictwo
:
Wydanie
:
Wstrząsoodporność
:
Wodoodporność
:
WIFI
:
Wielkość ekranu
:
Wersja językowa
:
Wejście słuchawkowe
:
Wariant
:
Tytuł oryginalny
:
Typ nośnika - elektronika
:
Typ matrycy
:
Typ ekspresu
:
Typ dysku twardego
:
Transmisja danych
:
Tracklista
:
Tłumacz
:
Tematyka/Przeznaczenie
:
Technologia ekranu
:
System operacyjny
:
Sukienki
:
Stroje kąpielowe
:
Stabilizator obrazu
:
Sposób zapięcia
:
Skarpety/Rajstopy
:
Skala
:
Seria
:
Ruchomy ekran LCD
:
Rozmiary konceptu
:
Rozmiar ramy
:
Rozmiar pieluch
:
Rozmiar koła
:
Rozdzielczość ekranu - komputery
:
Rozdzielczość
:
Rok wydania
:
Rodzaj zeszytu
:
Rodzaj zabezpieczenia
:
Rodzaj termometru
:
Rodzaj ramy
:
Rodzaj pieluch
:
Rodzaj perfum - Ona
:
Rodzaj perfum - On
:
Rodzaj nośnika
:
Rodzaj napędu
:
Rodzaj materiału
:
Rodzaj laktatora
:
Rodzaj krzesełka
:
Rodzaj kredek
:
Rodzaj kredek
:
Rodzaj kosmetyków
:
Rodzaj koła
:
Rodzaj farb
:
Rodzaj ekspresu
:
Rodzaj bloku
:
Reżyser
:
Puzzle temat
:
Liczba puzzli
:
Przekątna ekranu
:
Przebranie postać
:
Projektor
:
Procesor
:
Postać z gry
:
Postać pluszaka
:
Pojemność (ml)
:
Pojemność dysku twardego (GB)
:
Przedział wagowy
:
Maks. ciężar dziecka (kg)
:
Temat puzzli
:
Moc (W)
:
Podmiot odpowiedzialny
:
Opis bezpieczeństwa
:
Posiada logo CE. Nie nadaje się dla dzieci w wieku poniżej 3 lat. Zawiera małe elementy - ryzyko zadławienia.













/https://bin.smyk.com/media/static/WST%C4%84%C5%BBKI/10_przy_min_2_szt.png)




























